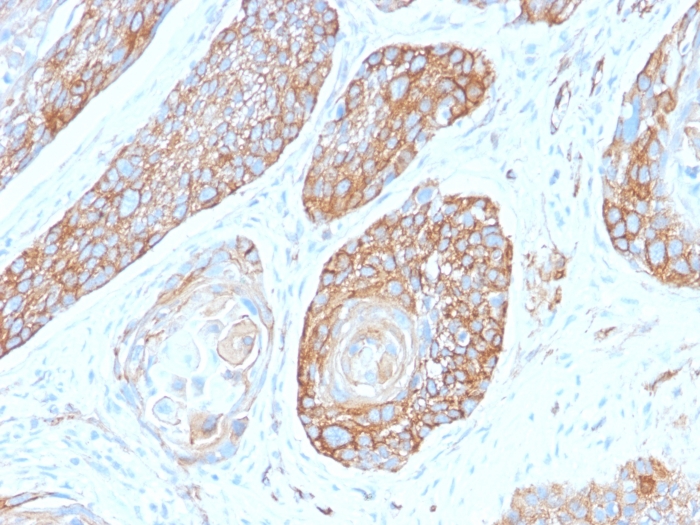

Formalin-fixed, paraffin-embedded human Pancreas stained with Spectrin Beta 3 Rabbit Monoclonal Antibody (SPTBN2/2979R).

Formalin-fixed, paraffin-embedded human Pancreas stained with Spectrin Beta 3 Rabbit Monoclonal Antibody (SPTBN2/2979R).

Western Blot Analysis of Human Kidney, Human Skin, Human Testis and HeLa lysates using Spectrin Beta 3 Recombinant Rabbit Monoclonal Antibody (SPTBN2/2979R).
Spectrin is an actin binding protein that is a major component of the plasma membrane skeleton. Spectrins function as membrane organizers and stabilizers by forming dimers, tetramers and higher polymers. Vertebrate spectrins have two alpha-subunits (alpha-I/alpha-II) four beta-subunits (beta-I-beta-IV) and a beta-H subunit creating diversity and specialization of function. Spectrin III is highly expressed in brain, kidney, pancreas and liver, and at lower levels in lung and placenta. Spectrin beta 3 is primarily expressed in nervous tissues with highest expression levels in the cerebellum, where it is found in Purkinje cell soma and dendrites.
There are no reviews yet.